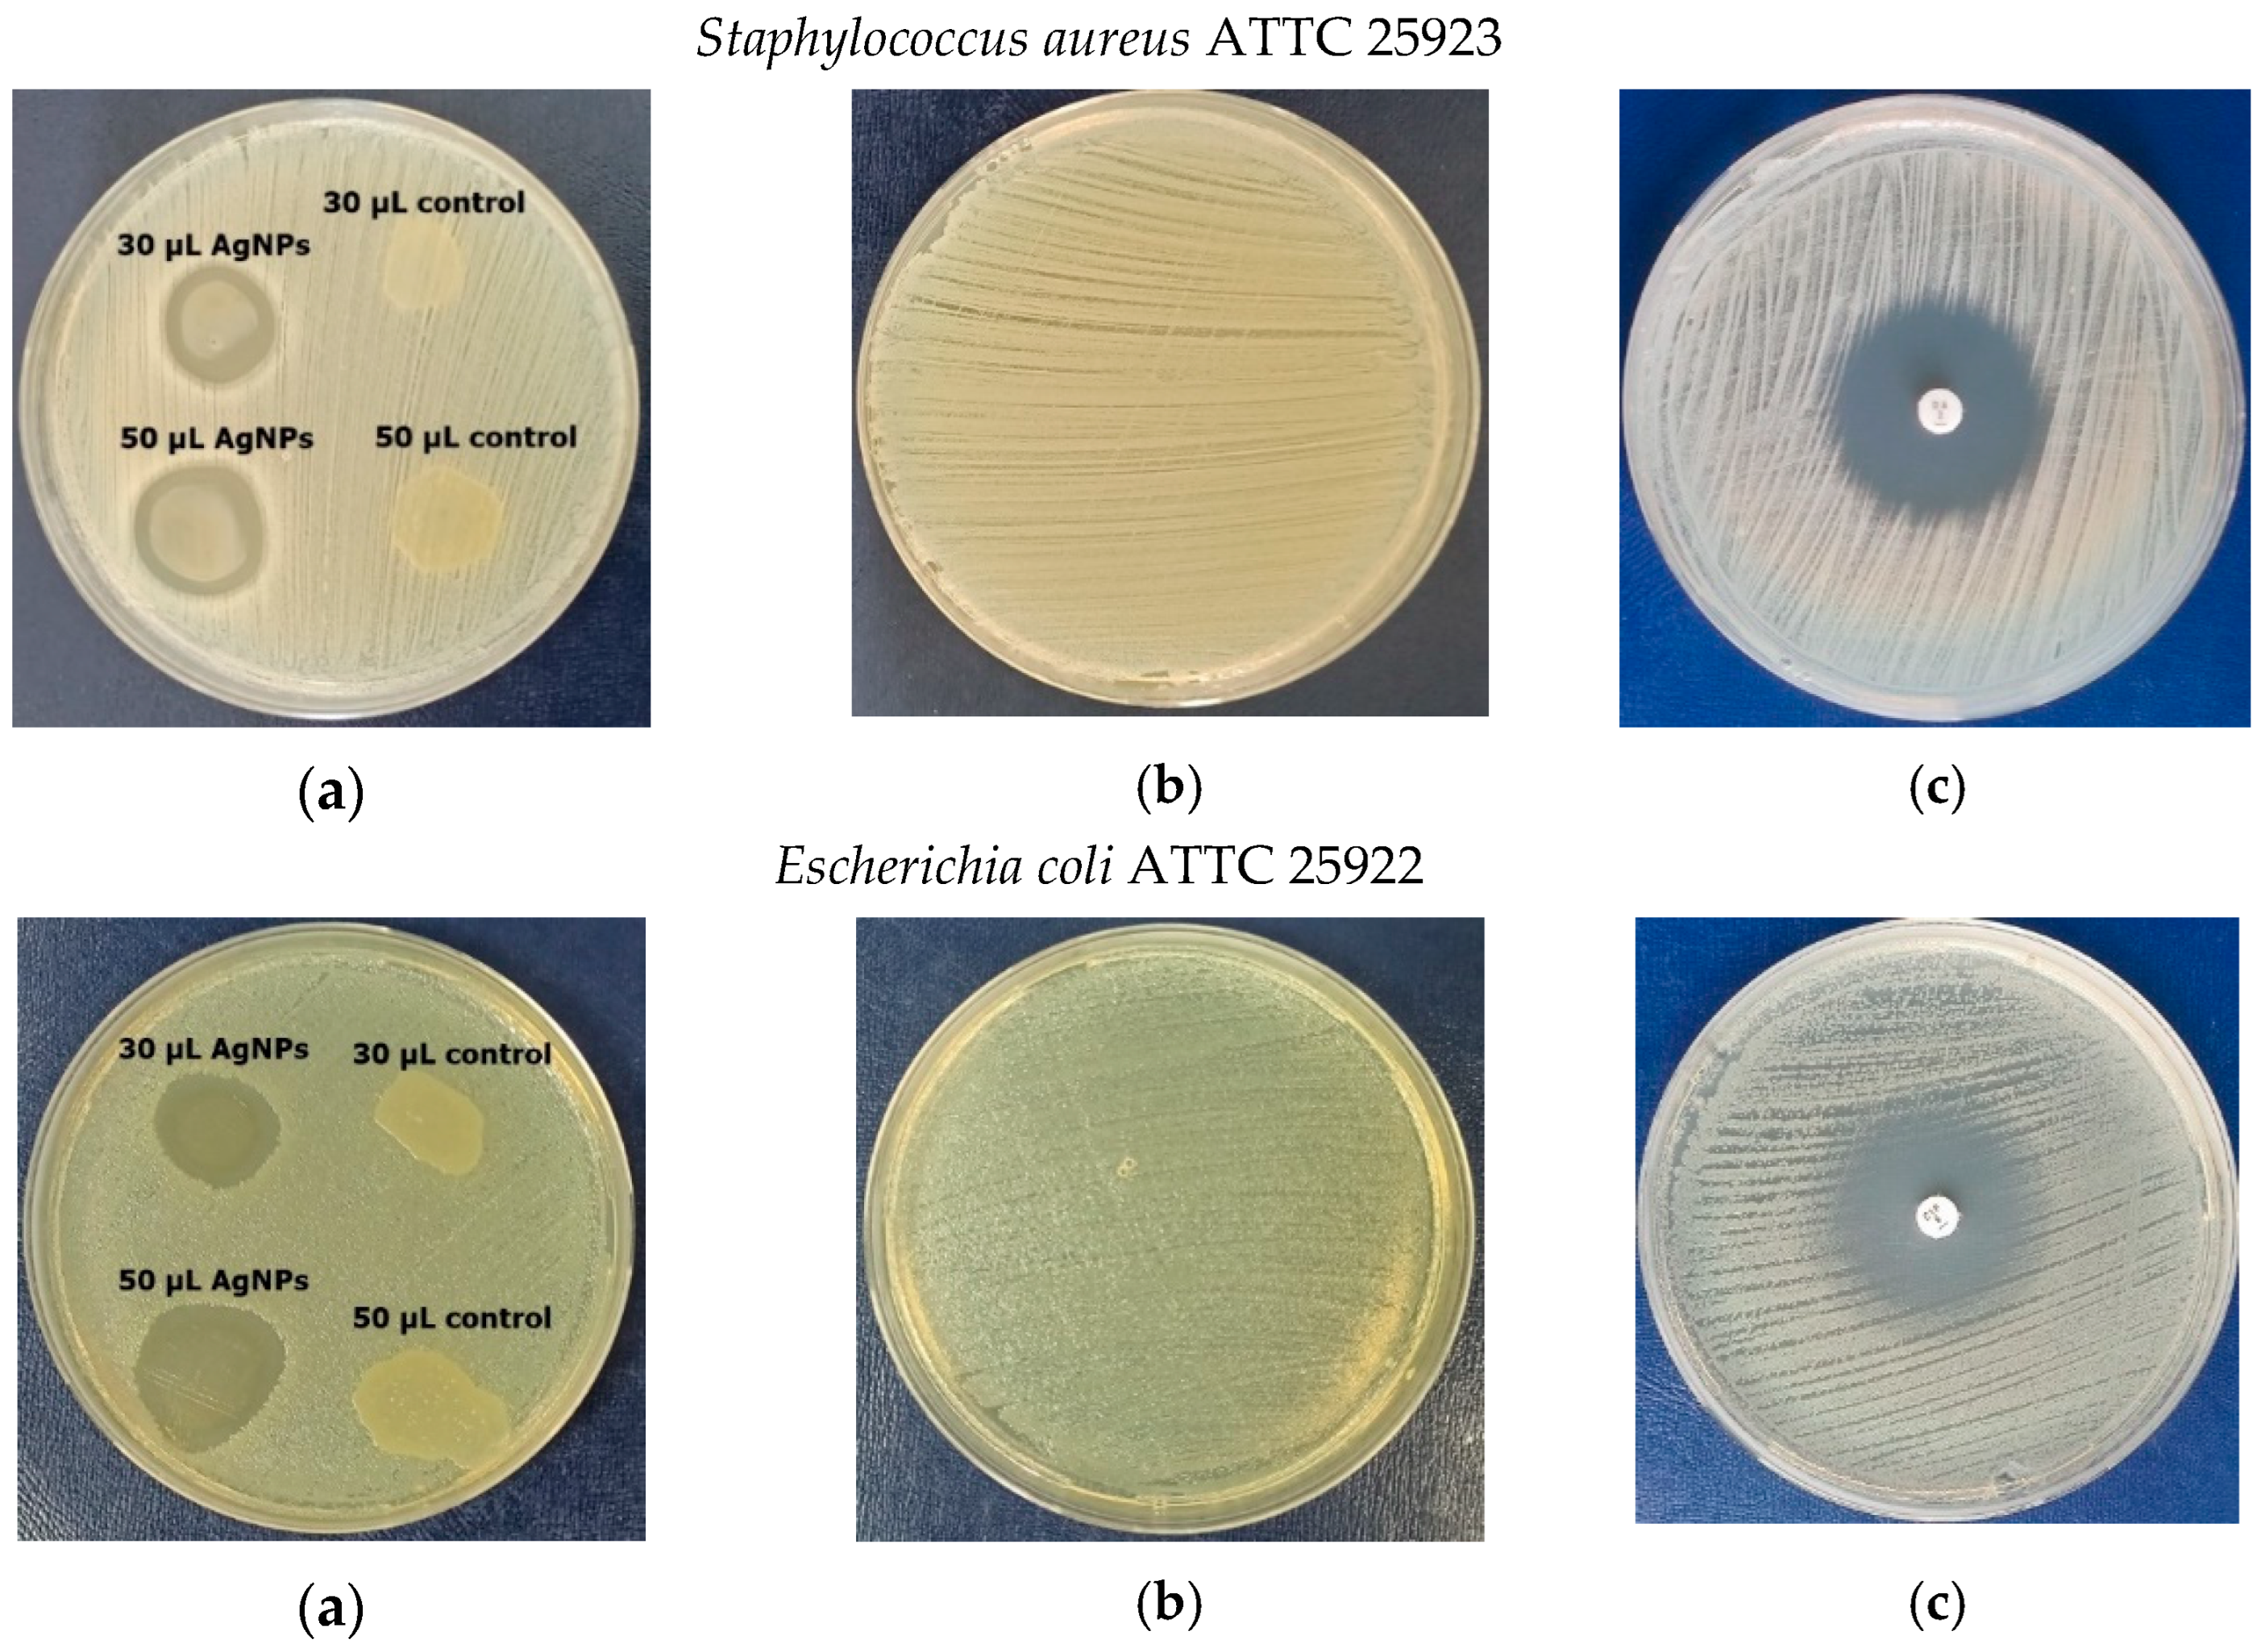
Materials 16 04261 g008a Materials 16 04261 g008a
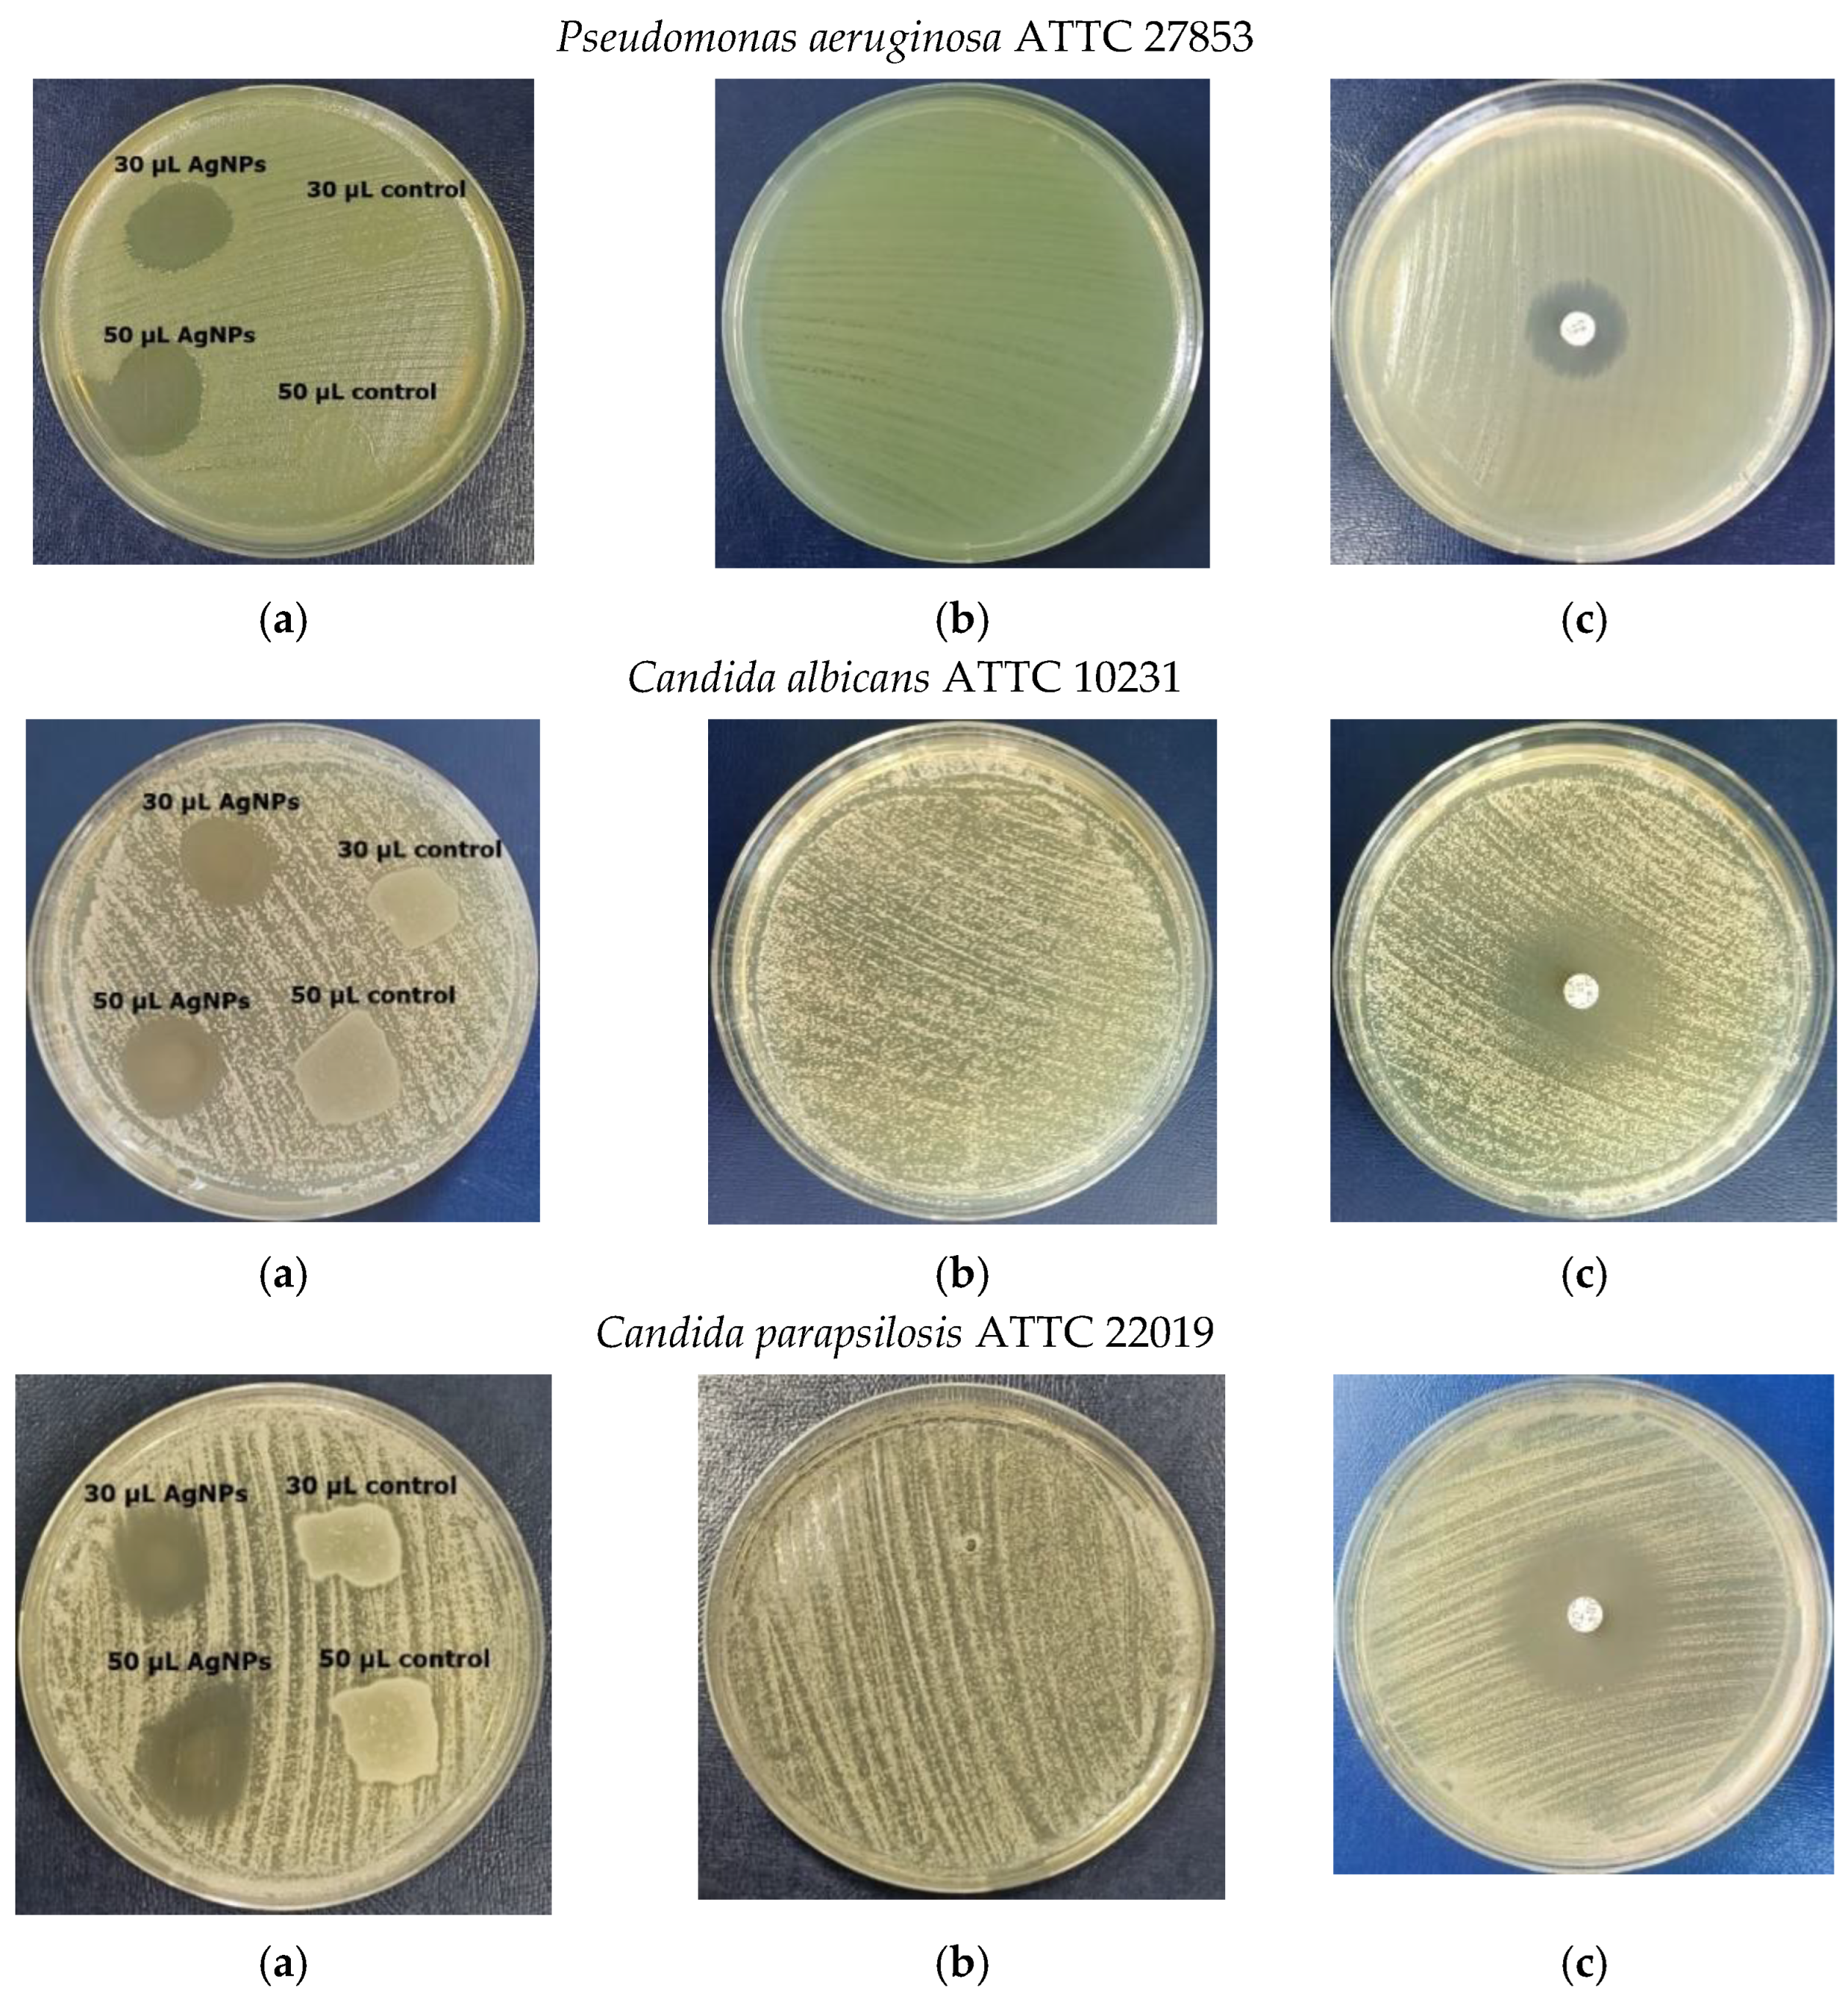
Materials 16 04261 g008b Materials 16 04261 g008b

Ganoderma lucidum-Mediated Green Synthesis of Silver Nanoparticles with Antimicrobial Activity
Abstract
1. Introduction
2. Materials and Methods
2.1. Cultivation of Ganoderma lucidum
2.2. Preparation of AgNPs
2.3. UV–VIS Spectroscopy Study
2.4. Fourier Transform Infrared Spectroscopy (FTIR) Analysis
2.5. XRD Analysis
2.6. Scanning Electron Microscopy (SEM)
2.7. Size Determination of Silver Nanoparticles
2.8. Antimicrobial Activity
3. Results
3.1. Synthesis of Silver Nanoparticles
3.2. Visual Observation of Colour Change during Green Synthesis
3.3. UV-Vis Spectra
3.4. FTIR Results
3.5. XRD Analysis
3.6. SEM Results
3.7. Dynamic Light Scattering (DLS) Analysis
3.8. Antimicrobial Activity
4. Discussion
5. Conclusions
Author Contributions
Funding
Institutional Review Board Statement
Informed Consent Statement
Data Availability Statement
Conflicts of Interest
References
- Franci, G.; Falanga, A.; Galdiera, S.; Palomba, L.; Rai, M.; Morelli, G.; Galdiera, M. Silver Nanoparticles as Potential Antibacterial Agents. Molecules 2015, 20, 8856–8874. [Google Scholar] [CrossRef] [PubMed]
- Roy, A.; Bulut, O.; Some, S.; Mandal, A.K.; Yilmaz, M.D. Green synthesis of silver nanoparticles: Biomolecule-nanoparticle organizations targeting antimicrobial activity. RSC Adv. 2019, 9, 2673. [Google Scholar] [CrossRef]
- Rónavári, A.; Igaz, N.; Adamecz, D.I.; Szerencsés, B.; Molnar, C.; Kónya, Z.; Pfeiffer, I.; Kiricsi, M. Green Silver and Gold Nanoparticles: Biological Synthesis Approaches and Potentials for Biomedical Applications. Molecules 2021, 26, 84. [Google Scholar] [CrossRef] [PubMed]
- Ahmad, S.A.; Das, S.S.; Khatoon, A.; Ansari, M.T.; Afzal, M.; Hasnain, M.S.; Nayak, A.K. Bactericidal activity of silver nanoparticles: A mechanistic review. Mater. Sci. Energy Technol. 2020, 3, 756–769. [Google Scholar] [CrossRef]
- Zhang, X.F.; Liu, Z.G.; Shen, W.; Gurunathan, S. Silver Nanoparticles: Synthesis, Characterization, Properties, Applications, and Therapeutic Approaches. Int. J. Mol. Sci. 2016, 17, 1534. [Google Scholar] [CrossRef]
- Sudheer, S.; Bai, R.G.; Muthoosamy, K.; Tuvikene, R.; Gupta, V.K.; Manickam, S. Bio sustainable production of nanoparticles via mycogenesis for biotechnological applications: A critical review. Environ. Res. 2022, 204, 111963. [Google Scholar] [CrossRef]
- Loshchinina, E.A.; Vetchinkina, E.P.; Kupryashina, M.A. Diversity of Biogenic Nanoparticles Obtained by the Fungi-Mediated Synthesis: A Review. Biomimetics 2023, 8, 1. [Google Scholar] [CrossRef]
- Santos, T.S.; Silva, T.M.; Cardoso, J.C.; Albuquerque-Júnior, R.L.C.; Zielinska, A.; Souto, E.B.; Severino, P.; Mendonça, M.d.C. Biosynthesis of Silver Nanoparticles Mediated by Entomopathogenic Fungi: Antimicrobial Resistance, Nanopesticides, and Toxicity. Antibiotics 2021, 10, 852. [Google Scholar] [CrossRef]
- Begum, S.J.P.; Pratibha, S.; Rawat, J.M.; Venugopal, D.; Sahu, P.; Gowda, A.; Qureshi, K.A.; Jaremko, M. Recent advances in green synthesis, characterization, and applications of bioactive metallic nanoparticles. Pharmaceuticals 2022, 15, 455. [Google Scholar] [CrossRef]
- Naganthran, A.; Verasoundarapandian, G.; Khalid, F.E.; Masarudin, M.J.; Zulkharnain, A.; Nawawi, N.M.; Karim, M.; Che Abdullah, C.A.; Ahmad, S.A. Synthesis, Characterization and Biomedical Application of Silver Nanoparticles. Materials 2022, 15, 427. [Google Scholar] [CrossRef]
- Xu, L.; Zhu, Z.; Sun, D.W. Bioinspired Nanomodification Strategies: Moving from Chemical-Based Agrosystems to Sustainable Agriculture. ACS Nano 2021, 15, 12655–12686. [Google Scholar] [CrossRef] [PubMed]
- Al-Ansari, M.M.; Dhasarathan, P.; Ranjitsingh, A.J.A.; Al-Humaid, L.A. Ganoderma lucidum inspired silver nanoparticles and its biomedical applications with special reference to drug resistant Escherichia coli isolates from CAUTI. Saudi J. Biol. Sci. 2020, 27, 2993–3002. [Google Scholar] [CrossRef] [PubMed]
- Bahrulolum, H.; Nooraei, S.; Javanshir, N.; Tarrahimofrad, H.; Mirbagheri, V.S.; Easton, A.J.; Ahmadian, G. Green Synthesis of Metal Nanoparticles Using Microorganisms and Their Application in the Agrifood Sector. J. Nanobiotechnol. 2021, 19, 86. [Google Scholar] [CrossRef] [PubMed]
- Jafar, N.B.; Fadhil, Z.H.; Mustafa, E.M.; Saadi, A.M. Investigation the inhibitory effects of AgNPs generated by Bifidobacterium spp. on bacteria isolated from ready-to-eat foods. Food Sci. Technol. Camp. 2022, 42, e88721. [Google Scholar] [CrossRef]
- Mohanta, Y.; Nayak, D.; Biswas, K.; Singdevsachan, S.; Abd Allah, E.; Hashem, A.; Alqarawi, A.; Yadav, D.; Mohanta, T. Silver nanoparticles synthesized using wild mushroom show potential antimicrobial activities against food borne pathogens. Molecules 2018, 23, 655. [Google Scholar] [CrossRef]
- Sharpe, E.; Farragher-Gnadt, A.P.; Igbanugo, M.; Huber, T.; Michelotti, J.C.; Milenkowic, A.; Ludlam, S.; Walker, M.; Hanes, D.; Bradley, R.; et al. Comparison of antioxidant activity and extraction techniques for commercially and laboratory prepared extracts from six mushroom species. J. Sci. Food Agric. 2021, 4, 100130. [Google Scholar] [CrossRef]
- Saba, I.; Zahoor, A.; Muhammad, Z.M.; Muhammad, M.; Zahra, F.; Ahmad, A. Optimization for biogenic microbial synthesis of silver nanoparticles through response surface methodology, characterization, their antimicrobial, antioxidant, and catalytic potential. Sci. Rep. 2021, 11, 770. [Google Scholar] [CrossRef]
- El-Bendary, M.A.; Afifi, S.S.; Moharam, M.E.; Abo Elsoud, M.M.; Gawdat, N.A. Optimization of Bacillus subtilis NRC1 growth conditions using response surface methodology for sustainable biosynthesis of gold nanoparticles. Sci. Rep. 2022, 12, 20882. [Google Scholar] [CrossRef]
- John, M.S.; Nagoth, J.A.; Ramasamy, K.P.; Mancini, A.; Giuli, G.; Miceli, C.; Pucciarelli, S. Synthesis of Bioactive Silver Nanoparticles Using New Bacterial Strains from an Antarctic Consortium. Mar. Drugs 2022, 20, 558. [Google Scholar] [CrossRef]
- Kulkarni, R.; Deobagkar, D.; Zinjarde, S. Nanoparticles derived from Rhodococcus roppenstedtii as bioactive agents for controlling aquaculture associated bacterial pathogens. Aquaculture 2022, 547, 737538. [Google Scholar] [CrossRef]
- Moghaddam, A.B.; Namvar, F.; Moniri, M.; Md Tahir, P.; Azizi, S.; Mohamad, R. Nanoparticles Biosynthesized by Fungi and Yeast: A Review of Their Preparation, Propr and Medical Applications. Molecules 2015, 20, 16540–16565. [Google Scholar] [CrossRef] [PubMed]
- Husseiny, S.F.; Salah, T.A.; Anter, H.A. Biosynthesis of size-controlled silver nanoparticles by Fusarium oxysporum, their antibacterial and antitumor activities. Beni-Suef Univ. J. Basic Appl. Sci. 2015, 4, 225–231. [Google Scholar] [CrossRef]
- Yassin, M.A.; Elgorban, A.M.; El-Samawaty, A.R.M.A.; Almunqedhi, B.M.A. Biosynthesis of silver nanoparticles using Penicillium verrucosum and analysis of their antifungal activity. Saudi J. Biol. Sci. 2021, 28, 2123–2127. [Google Scholar] [CrossRef] [PubMed]
- Sharma, A.; Sagar, A.; Rana, J.; Rani, R. Green synthesis of silver nanoparticles and its antibacterial activity using fungus Talaromyces purpureogenus isolated from Taxus baccata Linn. Micro Nano Syst. Lett. 2022, 10, 2. [Google Scholar] [CrossRef]
- Shahzad, A.; Saeed, H.; Iqtedar, M.; Hussain, S.Z.; Kaleem, A.; Abdullah, R. Size-controlled production of silver nanoparticles by Aspergillus fumigatus BTCB10: Likely antibacterial and cytotoxic effects. J. Nanomater. 2019, 2019, 5168698. [Google Scholar] [CrossRef]
- Lotfy, W.A.; Alkersh, B.M.; Sabry, S.A.; Ghozlan, H.A. Biosynthesis of Silver Nanoparticles by Aspergillus terreus: Characterization, Optimization, and Biological Activities. Front. Bioeng. Biotechnol. 2021, 9, 633468. [Google Scholar] [CrossRef]
- Othman, A.M.; Elsayed, M.A.; Al-Balakocy, N.G.; Hassan, M.H.; Elshafei, A.M. Biosynthesis and characterization of silver nanoparticles induced by fungal protein and its application in different biological activities. J. Genet. Eng. Biotechnol. 2019, 17, 8. [Google Scholar] [CrossRef]
- Dandapat, S.; Kumar, M.; Ranjan, R.; Sinha, M.P. Ganoderma applanatum extract mediated synthesis of silver nanoparticles. Braz. J. Pharm. Sci. 2022, 58, e19173. [Google Scholar] [CrossRef]
- Dat, T.D.; Viet, N.D.; Dat, N.M.; My, P.L.T.; Thinh, D.B.; Thy, L.T.M.; Huong, L.M.; Khang, P.T.; Hai, N.D.; Nam, H.M.; et al. Characterization and bioactivities of silver nanoparticles green synthesized from Vietnamese Ganoderma lucidum. Surf. Interfaces 2021, 27, 101453. [Google Scholar] [CrossRef]
- Jogaiah, S.; Kurjogi, M.; Abdelrahman, M.; Hanumanthappa, N.; Tran, L.-S.P. Ganoderma applanatum-mediated green synthesis of silver nanoparticles: Structural characterization, and in vitro and in vivo biomedical and agrochemical properties. Arab. J. Chem. 2019, 12, 1108–1120. [Google Scholar] [CrossRef]
- Nguyen, T.H.A.; Nguyen, V.-C.; Phan, T.N.H.; Le, V.T.; Vasseghian, Y.; Trubitsyn, M.A.; Nguyen, A.-T.; Chau, T.P.; Doan, V.-D. Novel biogenic silver and gold nanoparticles for multifunctional applications: Green synthesis, catalytic and antibacterial activity, and colorimetric detection of Fe (III) ions. Chemosphere 2022, 287, 132271. [Google Scholar] [CrossRef] [PubMed]
- Chopra, H.; Bibi, S.; Singh, I.; Hasan, M.M.; Khan, M.S.; Yousafi, Q.; Baig, A.A.; Rahman, M.M.; Islam, F.; Emran, T.B.; et al. Green Metallic Nanoparticles: Biosynthesis to Applications. Front. Bioen. Biotechnol. 2022, 10, 874742. [Google Scholar] [CrossRef] [PubMed]
- Balouiri, M.; Ssadiki, M.; Ibnsouda, S.K. Methods for in vitro evaluating antimicrobial activity: A review. J. Pharm. Anal. 2016, 6, 71–79. [Google Scholar] [CrossRef] [PubMed]
- Kharat, S.N.; Mendhulkar, V.D. Synthesis, characterization, and studies on antioxidant activity of silver nanoparticles using Elephantopus scaber leaf extract. Mater. Sci. Eng. 2016, C62, 719–724. [Google Scholar] [CrossRef] [PubMed]
- Njue, W.; Kithokoi, J.K.; Swaleh, S.; Mburu, J.; Mwangi, H. Green ultrasonic synthesis, Characterization and Antibacterial activity of Silver and Gold Nanoparticles mediated by Ganoderma lucidum extract. J. Appl. Mater. Sci. Eng. Res. 2020, 4, 41–45. [Google Scholar]
- Dakal, T.C.; Kumar, A.; Majumdar, R.S.; Yadav, V. Mechanistic Basis of Antimicrobial Actions of Silver Nanoparticles. Front. Microbiol. 2016, 7, 1831. [Google Scholar] [CrossRef]
- Tang, S.; Zheng, J. Antibacterial Activity of Silver Nanoparticles: Structural Effects. Adv. Healthc. Mater. 2018, 7, 1701503. [Google Scholar] [CrossRef]
- Crisan, C.M.; Mocan, T.; Manolea, M.; Lasca, L.I.; Tabaran, F.-A.; Mocan, L. Review on Silver Nanoparticles as a Novel Class of Antibacterial Solutions. Appl. Sci. 2021, 11, 1120. [Google Scholar] [CrossRef]
- Xin, X.; Qi, C.; Xu, L.; Gao, Q.; Liu, X. Green synthesis of silver nanoparticles and their antibacterial effects. Front. Chem. Eng. 2022, 4, 941240. [Google Scholar] [CrossRef]
- Logeswari, P.; Silambarasan, S.; Abraham, J. Synthesis of Silver nanoparticles using plants extracts and analysis of their antimicrobial property. J. Saudi. Chem. Soc. 2015, 19, 311–317. [Google Scholar] [CrossRef]
- Ibrahim, E.; Zhang, M.; Zhang, Y.; Hossain, A.; Qiu, W.; Chen, Y.; Wang, Y.; Wu, W.; Sun, G.; Li, B. Green-Synthesization of Silver Nanoparticles Using Endophytic Bacteria Isolated from Garlic and Its Antifungal Activity against Wheat Fusarium Head Blight Pathogen Fusarium Graminearum. Nanomaterials 2020, 10, 219. [Google Scholar] [CrossRef] [PubMed]
- Skanda, S.; Bharadwaj, P.S.J.; Datta Darshan, V.M.; Sivaramakrishnan, V.; Vijayakumar, B.S. Proficient mycogenic synthesis of silver nanoparticles by soil derived fungus Aspergillus melleus SSS-10 with cytotoxic and antibacterial potency. J. Microbiol. Methods 2022, 199, 106517. [Google Scholar] [CrossRef] [PubMed]
- Kitching, M.; Ramani, M.; Marsili, E. Fungal biosynthesis of gold nanoparticles: Mechanism and scale up. Microb. Biotechnol. 2015, 8, 904–917. [Google Scholar] [CrossRef] [PubMed]
- Zhu, Y.; Tan, A.T.L. Discrimination of wild-grown and cultivated Ganoderma lucidum by Fourier transform infrared spectroscopy and chemometric methods. Am. J. Anal. Chem. 2015, 6, 480–491. [Google Scholar] [CrossRef]
- Debnath, G.; Das, P.; Saha, A.K. Green synthesis of silver nanoparticles using mushroom extract of Pleurotus giganteus: Characterization, antimicrobial, and α-amylase inhibitory activity. BioNanoScience 2019, 9, 611–619. [Google Scholar] [CrossRef]
- Siddiqi, K.S.; Husen, A. Fabrication of metal nanoparticles from fungi and metal salts: Scope and application. Nanoscale Res. Lett. 2016, 11, 98. [Google Scholar] [CrossRef]
- Guilger-Casagrande, M.; De Lima, R. Synthesis of Silver Nanoparticles Mediated by Fungi: A Review. Front. Bioeng. Biotechnol. 2019, 7, art 287. [Google Scholar] [CrossRef]
- Murillo-Rábago, E.I.; Vilchis-Nestor, A.R.; Juarez-Moreno, K.; Garcia-Marin, L.E.; Quester, K.; Castro-Longoria, E. Optimized synthesis of small and stable silver nanoparticles using intracellular and extracellular components of fungi: An alternative for bacterial inhibition. Antibiotics 2022, 11, 800. [Google Scholar] [CrossRef]
- Aygün, A.; Özdemir, S.; Gülcan, M.; Cellat, K.; Șen, F. Synthesis and characterization of Reishi mushroom-mediated green synthesis of silver nanoparticles for the biochemical applications. J. Pharm. Biomed. Anal. 2019, 178, 112970. [Google Scholar] [CrossRef]
- Marie, S.M.; Al Anbagi, R.A.; Suliaman, S.Q. Silver nanoparticles synthesized from Polyporus plorans, a wild mushroom with detecting its physio-chemical characterization and antimicrobial activities. Egypt. Acad. J. Biol. Sci. 2023, 15, 43–59. [Google Scholar] [CrossRef]
- Dhara, B.; Roy, I.; Maity, A. Comparative account of the genotoxic and antimicrobial effects of silver nanoparticles synthesized from extract of Pleurotus Ostreatus and chemically synthesized nanoparticles. Cell Tiss. Biol. 2021, 15, 77–89. [Google Scholar] [CrossRef]

Disclaimer/Publisher’s Note: The statements, opinions and data contained in all publications are solely those of the individual author(s) and contributor(s) and not of MDPI and/or the editor(s). MDPI and/or the editor(s) disclaim responsibility for any injury to people or property resulting from any ideas, methods, instructions or products referred to in the content. |
© 2023 by the authors. Licensee MDPI, Basel, Switzerland. This article is an open access article distributed under the terms and conditions of the Creative Commons Attribution (CC BY) license (https://creativecommons.org/licenses/by/4.0/).
Share and Cite
Constantin, M.; Răut, I.; Suica-Bunghez, R.; Firinca, C.; Radu, N.; Gurban, A.-M.; Preda, S.; Alexandrescu, E.; Doni, M.; Jecu, L. Ganoderma lucidum-Mediated Green Synthesis of Silver Nanoparticles with Antimicrobial Activity. Materials 2023, 16, 4261. https://doi.org/10.3390/ma16124261
Constantin M, Răut I, Suica-Bunghez R, Firinca C, Radu N, Gurban A-M, Preda S, Alexandrescu E, Doni M, Jecu L. Ganoderma lucidum-Mediated Green Synthesis of Silver Nanoparticles with Antimicrobial Activity. Materials. 2023; 16(12):4261. https://doi.org/10.3390/ma16124261
Chicago/Turabian StyleConstantin, Mariana, Iuliana Răut, Raluca Suica-Bunghez, Cristina Firinca, Nicoleta Radu, Ana-Maria Gurban, Silviu Preda, Elvira Alexandrescu, Mihaela Doni, and Luiza Jecu. 2023. "Ganoderma lucidum-Mediated Green Synthesis of Silver Nanoparticles with Antimicrobial Activity" Materials 16, no. 12: 4261. https://doi.org/10.3390/ma16124261
APA StyleConstantin, M., Răut, I., Suica-Bunghez, R., Firinca, C., Radu, N., Gurban, A.-M., Preda, S., Alexandrescu, E., Doni, M., & Jecu, L. (2023). Ganoderma lucidum-Mediated Green Synthesis of Silver Nanoparticles with Antimicrobial Activity. Materials, 16(12), 4261. https://doi.org/10.3390/ma16124261

